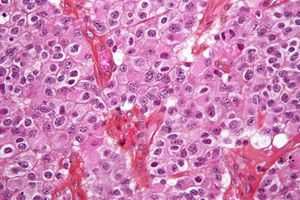

ورم المخ
| Eyad ساهم بشكل رئيسي في تحرير هذا المقال
|
| ورم المخ | |
|---|---|
| Brain metastasis in the right cerebral hemisphere from lung cancer shown on T1-weighted magnetic resonance imaging with intravenous contrast. (L=left, P=posterior, back of the head) | |
| التبويب والمصادر الخارجية | |
| التخصص | علم الأورام, جراحة المخ والأعصاب, طب الجهاز العصبي |
| ICD-10 | C71., D33.0-D33.2 |
| ICD-9-CM | 191, 225.0 |
| DiseasesDB | 30781 |
| MedlinePlus | 007222 000768 |
| eMedicine | emerg/334 |
| Patient UK | فشل عرض الخاصية P1461: لم يتم العثور على الخاصية P1461. ورم المخ |
| MeSH | D001932 |

سرطان الدماغ Brain Tumor، هو إنقسام غير طبيعي وغير منتظم لخلايا الدماغ سواء في المخ أو المخيخ أو الحبل الشوكي والذي يسبب إنضغاط لأجزاء الدماغ الأخرى و بالتالي فقدان لإحدى الوظائف أو ضعفها.
وأورام الدماغ الأولية (أي التي منشأها الأصلي الدماغ) نادرة جداً، بعكس أورام الدماغ الثانوية التي تكون ناتجة عن إنتشار الورم من أعضاء أخرى بالجسم وصولاً إلى الدماغ.
تقسيم سرطان الدماغ
حسب مكان ومنشأ الورد
أورام ثانوية
حسب سلوك الورم
الأورام الدماغية الحميدة
الأورام هنا لا تحتوي على خلايا سرطانية وتبدو طبيعية تحت المجهر ونموها بطيئ عادة.
الأورام الدماغية الخبيثة
وهي التي تسمى سرطان الدماغ، تنمو بسرعة وتغزو في أغلب الأحيان أو تتكاثرفي مناطق سليمة من الدماغ.
تطور الورم حسب نوع النسيج

في طب الأطفال
الأسباب
ليس له أسباب معروفه حتى الآن. ولكن قد تتدخل بعض العوامل البيئية أو الوراثية.
الهاتف النقال
في يونيو 2011 أعلنت لجنة تابعة لمنظمة الصحة العالمية إلى إمكانية وجود علاقة بين استخدام الهواتف النقالة والإصابة بسرطان المخ. وقد وضع تقرير المنظمة الهواتف النقالة في نفس فئة المبيد الحشري دي دي تي والعوادم النتائجة عن محركات البنزين. وقال العلماء ان هذه النتيجة قد تدفع منظمة الصحة العالمية لاعادة النظر في إرشاداتها بشأن الهواتف النقالة، لكنهم أضافوا أنه من الضروري اجراء مزيد من الأبحث قبل الجزم بوجود أي ارتباط محتمل.[1]
ولقيت هذه النتائج المجموعة رفضا شديدا من جانب الرابطة الدولية لصناعة الاتصالات اللاسلكية (سي تي آي إيه). وقال جوناثان سامت، رئيس مجموعة الوكالة الدولية لأبحاث السرطان، في بيان عبر الهاتف «بعد مراجعة جميع الأدلة ذات الصلة بشكل أساسي صنف فريق العمل مجالات الموجات الكهرومغناطيسية اللاسلكية على أنها يحتمل أن تسبب السرطان للبشر». وقال إن بعض الأدلة تشير إلى وجود صلة بين زيادة خطر الإصابة بورم دبقي، وهو نوع من أنواع سرطان الدماغ، واستخدام الهاتف الجوال. وقالت الرابطة في بيان «أجرت الوكالة الدولية لأبحاث السرطان مراجعات كثيرة في الماضي وطرحت النتيجة نفسها بالنسبة للخضراوات المخللة والقهوة». وأضافت أن لجنة الاتصالات الاتحادية الأميركية وإدارة الغذاء والدواء لم تعثرا على دليل علمي يربط ما بين الهواتف النقالة والإصابة بالسرطان. وقال نائب رئيس الرابطة جون وولز «هذا التصنيف لا يعني أن الهواتف لنقالة تسبب السرطان».
خصائص الأورام
الأعراض والعلامات
أورام الدماغ سواءً كانت حميدة او خبيثة تتسبب بأعراض متشابهة والتي تختلف بحسب مكان حدوثها من الدماغ. ومن هذه الأعراض:
- الصداع خاصةً الذي يصيب الشخص صباحاً.
- الغثيان و التقيؤ.
- حدوث تشنجات.
- ضعف بعض الأطراف كالعلوية أو السفلية.
- ضعف بعض الحواس أو تأثرها.
| الإشارات المزعجة | السبب المحتمل ليُستقصَى |
|---|---|
| أول شكوى من صداع من مريض فوق الخمسين | arteriïtis temporalis] |
| أول نوبة صداع نصفي في مريض فوق الأربعين | ورم في المخ |
| صداع من مريض تحت السادسة | ورم في المخ، hydrocephalus |
| مريض عجوز مع ألم في الصدغين | arteriïtis temporalis |
| حمل مع صداع غير معروف | pre-eclampsia |
| increased headaches after trauma | sub/epidural hematoma |
| high-pitched headaches with high blood pressure | malign hypertension |
| acute high pitched headache | meningitis, CVA (Cerebrovascular accident or stroke), subarachnoidal hemorrhage |
| headache and fever (with reduced consciousness) | meningitis |
| Stiffness of the neck/neurological dysfunction | meningitis, ورم في المخ |
| headache with signs of elevated intracranial pressure | ورم في المخ |
| focal neurological dysfunction | ورم في المخ |
| early morning vomiting or vomiting unrelated to headache or other illness | ورم في المخ |
| behavioral changes or rapid decline in school results | ورم في المخ |
| aura migraine always at one side | ورم في المخ |
ورم أرومي دبقي
مقالة مفصلة: ورم أرومي دبقي
ورم الدبقيات القليلة التغصن
مقالة مفصلة: ورم الدبقيات القليلة التغصن
التشخيص
of an oligodendroglioma, a type of brain cancer. Brain biopsy. H&E stain.]]
عن عمل أشعة مقطعية للرأس للتأكد من وجود ورم بعد عمل الفحص السريري. كما ان فحص الجهاز العصبي مهم حتى يمكن معرفة مكان الإصابة في الدماغ.
ومن الفحوص الأخرى التي يمكن اجراؤها هو حقن مادة ملونة في احد الشرايين المغذية للمخ ثم تصوير الرأس حيث تظهر كافة الشرايين هناك، وهذا الفحص يجرى عادةً إذا كان هناك نية لإجراء عملية جراحية لاستئصال الورم.
العلاج
العلاج الجراجي
التدخل الجراحي لإستئصال الورم إذا كان موضعي لإزالة الضغط الواقع على الأجزاء الأخرى. ولكن احياناً يكون من الصعب اجراء العملية اذا كان الورم قريب من مكان حيوي هام في المخ.
العلاج الإشعاعي
العلاج الإشعاعي وقد تم في العقدين الماضيين تطوير تقنيات جديدة في العلاج الإشعاعي بحيث يتم استهداف منطقة الورم الدماغي دون أذية الأنسجة السليمة المجاورة يستعمل في العلاج الإشعاعي التقليدي أشعة خارجية كالأشعة السينية أو أشعة غاما أو بروتونات تستهدف الورم لقتل خلايا السرطان وتقلص الأورام الدماغية. إن العلاج يعطي عادة على فترة عدة أسابيع.
العلاج الكيميائي
العلاج الكيميائي مع ان الفائدة منه محدودة حيث ان العقاقير والمواد الفعالة لا يمكنها الدخول الى المخ عن طريق الأوعية الدموية بسبب الحاجز الدماغي الدموي ولكن يمكن حقن العقار أو الدواء في السائل الدماغي الشوكي.
أنواع أخرى
الإنتشار
| القياس | الجنس | DASR | كل الأعمار | تحت 1 | 1-4 | 5-9 | 10-14 | 15-19 | 20-24 | 25-29 | 30-34 | 35-39 | 40-44 | 45-49 | 50-54 | 55-59 | 60-64 | 65-69 | 70-74 | 75-79 | 80-84 | 85+ |
|---|---|---|---|---|---|---|---|---|---|---|---|---|---|---|---|---|---|---|---|---|---|---|
| أرقام مطلقة | ذ | 2.13 | 7 | 34 | 39 | 31 | 37 | 33 | 48 | 61 | 87 | 100 | 116.1 | 142 | 242 | 264 | 258 | 237 | 193 | 128 | 73 | |
| م | 1.598 | 7 | 42 | 39 | 37 | 28 | 25 | 37 | 50 | 42 | 73 | 87 | 99 | 140 | 191 | 166 | 169 | 158 | 111 | 97 | ||
| المعدلات لكل 100.000 نسمة | M | 7,7 | 8,5 | 2,1 | 2,8 | 2,7 | 2,0 | 2,1 | 1,9 | 2,8 | 3,7 | 4,6 | 5,1 | 6,6 | 9,3 | 15,7 | 18,6 | 24,0 | 25,8 | 26,7 | 26,6 | 21,2 |
| F | 5,3 | 6,2 | 2,2 | 3,6 | 2,8 | 2,5 | 1,7 | 1,5 | 2,2 | 3,0 | 2,2 | 3,7 | 4,9 | 6,3 | 8,8 | 12,9 | 14,3 | 16,2 | 17,1 | 15,1 | 12,8 |
انظر أيضا
- Craterization
- قائمة أشهر المصابين بسرطان الدماغ
- Radiosurgery
- Stereotactic surgery
- علاج إشعاعي
- Grading of the tumors of the central nervous system
- Visualase Laser Technology for Tumor Ablation (LITT)
المصادر
- ^ "مصنعون يشككون في وجود علاقة بين الهواتف الجوالة والإصابة بالسرطان". جريدة الشرق الأوسط. 2011-06-03. Retrieved 2011-06-03.
وصلات خارجية
- American Brain Tumor Association The American Brain Tumor Association exists to eliminate brain tumors through research and to meet the needs of brain tumor patients and their families.
- National Brain Tumor Society National Brain Tumor Society (NBTS) brings together the best of research and patient services to be a comprehensive resource for patients, families, caregivers, researchers, and medical professionals.
- UWO Brain tumors, Approach to..
- Management Neuro-oncology disorders
- Brain Cancer Vaccine Video
- The Brain Tumor Trials Collaborative: Brain Tumor Research
- Brain and CNS cancers at the Open Directory Project
- WebMD: Brain Cancer Health Center
- Medical Image Database MR and CT Scans of Brain Tumors
- Seattle's Ivy Center for Advanced Brain Tumor Treatment
- Medical Encyclopedia MayoClinic: Brain tumor
- Brain Tumor: Definitions Neurosurgery UCLA
- Medline Plus: Brain Cancer – Interactive Health Tutorials
- Cancer.Net: Brain Tumor - Patient information from the American Society of Clinical Oncology
- Visualase Laser Technology For Thermal Tumor Ablation
- Brain Tumor Locations Differential Diagnosis
- MedPix Teaching File MR Scans of Primary Brain Lymphoma
- Brain Tumour Foundation of Canada Support, education, information and research
- Samantha Dickson Brain Tumour Trust UK charity offering support, education, information and research
- Clinical Trials & Noteworthy Treatments For Brain Tumors Run by the Musella Foundation For Brain Tumor Research & Information, Inc - offers a free Guide for the Newly Diagnosed Brain Tumor Patient, origina
- Brain Cancer.org Find news and information on brain cancer/tumor, symptoms, causes, signs, diagnosis, and support
- Brain Tumor Surgery Video
- Brain Tumour Alliance Australia - brain tumour patient and caregiver organisation in Australia